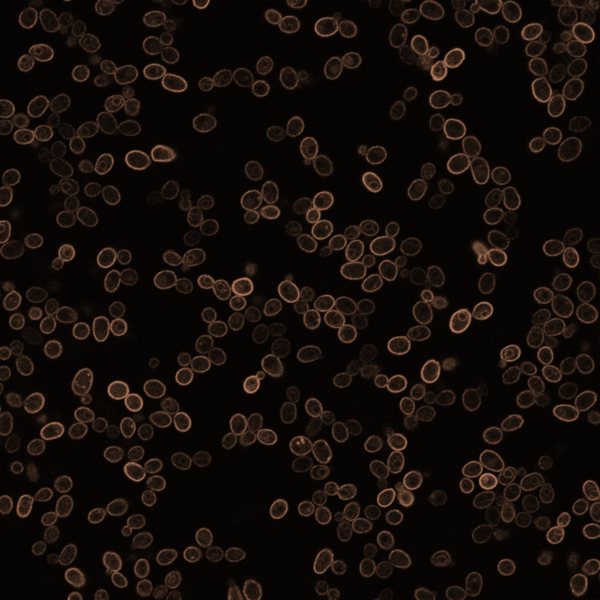
decorative Image of fluorescent yeast cells

Wasko Lab
Our lab uncovers how cells stay healthy and why they fail during aging and disease. With yeast cells as our model, we explore conserved molecular pathways, screen for new therapeutic drugs, and model rare human genetic disorders. We also use yeast to create real-world research experiences to train and inspire future scientists.